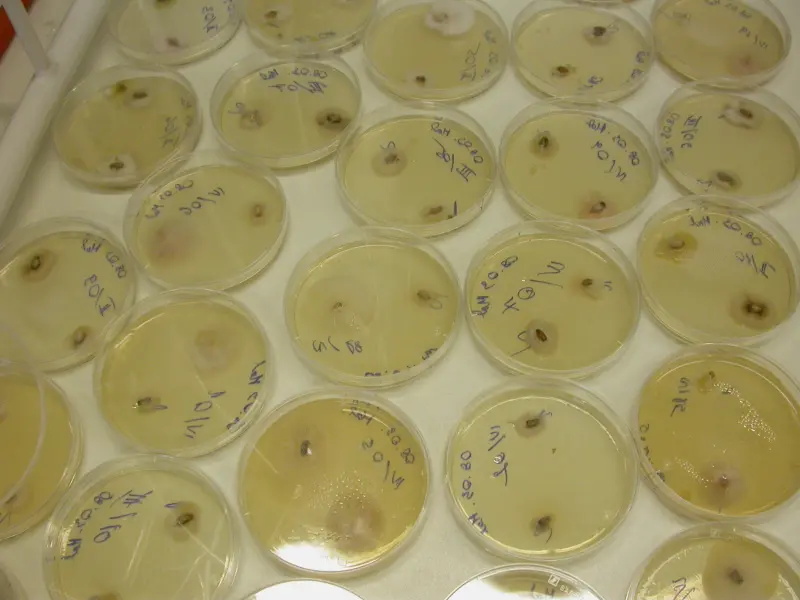

Az Agrárműszerközpont oktatói aktívan részt vesznek a Kar oktatási feladatainak ellátásában mind BSc mind MSc szinten, ezenkívül a szakközépiskolások ismereteinek bővítésében is részt vállalunk különböző szakmai kirándulások helyszíneként. Érdeklődő hallgatók szakdolgozatának, diplomamunkájának vezetését vállaljuk. Az Egyetem doktori iskoláinak munkáját mind doktorandusz képzéssel, mind a kutatómunka helyszíneként segítjük.
Szakdolgozatok, diplomamunkák
A DE MÉK Agrárműszerközpont keretein belül Dr. Pusztahelyi Tünde egyetemi docens vezetésével a következő tudományos témák kerülnek meghirdetésre.
- Aflatoxin képzés fiziológiai vizsgálata Aspergillus tenyészeteken.
- Tejsavbaktériumok stressztoleranciájának növelése és ennek hatása oligoszacharid hasznosításukra.
- Gazdanövény - Aspergillus flavus interakció (irodalmi gyűjtés és kísérletes munka).
- Zsírsavösszetétel vizsgálata GC módszerrel élelmiszerekben.
Legutóbbi frissítés:
2022. 08. 01. 19:31